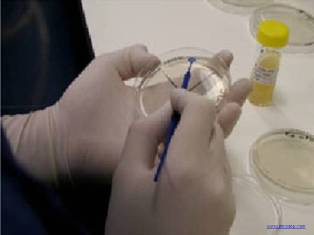

MICLAB-140
This document deals with the correct means of maintaining a culture collection with an emphasis on aseptic practices in the laboratory.
MICLAB-140 Maintenance of Culture Collection

This document deals with the correct means of maintaining a culture collection with an emphasis on aseptic practices in the laboratory.